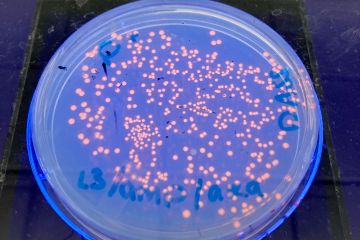

Explore biology and biotechnology materials and resources developed by our ABE program sites. We have many resources to share. Please come back regularly to check out the new additions!!

ABE Kit Pack Up Guide
This short guide gives instructions to teachers on how to effectively pack up their ABE kit to ensure items are returned in good condition. Read more
Type(s): Professional Learning/Support
Topic(s): ABE Program
Program Site(s): ABE Canada

Teacher Refresher Questions
Refresher questions for teachers before they pick up the ABE kit. These questions help sites to ensure that teachers understand how to properly store equipment and reagents in order to improve the… Read more
Type(s): Professional Learning/Support
Topic(s): ABE Program, Program Sites, Teacher Experiences
Program Site(s): ABE Australia

Micropipetting Practice Stations
This activity allows students to practice their pipetting skills at a series of different "stations". Read more
Type(s): Teaching Materials, Lab-based
Topic(s): Lab Techniques, Pipetting
Education Levels: Lower Secondary, Upper Secondary, Introductory, Advanced
Program Site(s): ABE Massachusetts

Micropipetting Practice Card
Micropipetting practice card. Tarjeta de prácticas de micropipeteo. Read more
Type(s): Teaching Materials, Lab-based
Topic(s): Pipetting
Education Levels: Lower Secondary, Upper Secondary, Introductory, Advanced
Program Site(s): ABE Mexico
Competent Cell Hacks
Tips and tricks for transporting, storing and using competent cells to improve transformation results. Read more
Type(s): Professional Learning/Support
Topic(s): ABE Program, Program Sites, Transformation
Program Site(s): ABE Singapore, ABE Greater Los Angeles Area